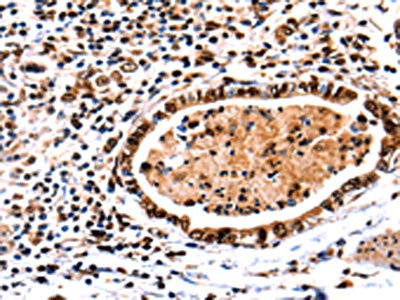

DNMT3A Antibody
-
中文名稱:DNMT3A兔多克隆抗體
-
貨號:CSB-PA094007
-
規(guī)格:¥1100
-
圖片:
-
其他:
產(chǎn)品詳情
-
Uniprot No.:
-
基因名:
-
別名:DNA (cytosine 5) methyltransferase 3 alpha antibody; DNA (cytosine 5) methyltransferase 3A antibody; DNA (cytosine-5)-methyltransferase 3A antibody; DNA cytosine methyltransferase 3A2 antibody; DNA methyltransferase 3 alpha antibody; DNA methyltransferase 3a antibody; DNA methyltransferase HsaIIIA antibody; DNA MTase HsaIIIA antibody; DNM3A_HUMAN antibody; DNMT 3a antibody; DNMT antibody; Dnmt3a antibody; DNMT3A2 antibody; M.HsaIIIA antibody; MCMT antibody; OTTHUMP00000201149 antibody; TBRS antibody
-
宿主:Rabbit
-
反應(yīng)種屬:Human,Mouse,Rat
-
免疫原:Fusion protein of Human DNMT3A
-
免疫原種屬:Homo sapiens (Human)
-
標記方式:Non-conjugated
-
抗體亞型:IgG
-
純化方式:Antigen affinity purification
-
濃度:It differs from different batches. Please contact us to confirm it.
-
保存緩沖液:-20°C, pH7.4 PBS, 0.05% NaN3, 40% Glycerol
-
產(chǎn)品提供形式:Liquid
-
應(yīng)用范圍:ELISA,IHC
-
推薦稀釋比:
Application Recommended Dilution ELISA 1:2000-1:5000 IHC 1:100-1:300 -
Protocols:
-
儲存條件:Upon receipt, store at -20°C or -80°C. Avoid repeated freeze.
-
貨期:Basically, we can dispatch the products out in 1-3 working days after receiving your orders. Delivery time maybe differs from different purchasing way or location, please kindly consult your local distributors for specific delivery time.
-
用途:For Research Use Only. Not for use in diagnostic or therapeutic procedures.
相關(guān)產(chǎn)品
靶點詳情
-
功能:Required for genome-wide de novo methylation and is essential for the establishment of DNA methylation patterns during development. DNA methylation is coordinated with methylation of histones. It modifies DNA in a non-processive manner and also methylates non-CpG sites. May preferentially methylate DNA linker between 2 nucleosomal cores and is inhibited by histone H1. Plays a role in paternal and maternal imprinting. Required for methylation of most imprinted loci in germ cells. Acts as a transcriptional corepressor for ZBTB18. Recruited to trimethylated 'Lys-36' of histone H3 (H3K36me3) sites. Can actively repress transcription through the recruitment of HDAC activity. Also has weak auto-methylation activity on Cys-710 in absence of DNA.
-
基因功能參考文獻:
- Multiple evidences suggested that PRMT5 repressed transcription of tumor suppressor IRX1 via recruitment of DNMT3A on promoter. PMID: 29802960
- Most had constantly high DNMT3A(mut) transcript levels. PMID: 28643785
- Together findings presented here recognize an inherent role of MTA1 as a modifier of DNMT3a and IGFBP3 expression, and consequently, the role of MTA1-DNMT3a-IGFBP3 axis in breast cancer progression. PMID: 28393842
- we developed a modular dCas9-SunTag (dC9Sun-D3A) system that can recruit multiple DNMT3A catalytic domains to a target site for editing DNA methylation. dC9Sun-D3A is tunable, specific, and exhibits much higher induction of DNA methylation at target sites than the dC9-D3A direct fusion protein. PMID: 29907613
- Results indicate that DNMT3A mutations alone do not affect the clinical outcomes of AML patients undergoing allogeneic HSCT, but when accompanied by FLT3-ITD mutations, the OS was significantly reduced (5-year OS 0% for DNMT3A R882mut/FLT3-ITDpos patients vs. 62% DNMT3A R882wt/FLT3-ITDneg, p=0.025) and the relapse rate increased. PMID: 29786546
- Genetic variation in DNMT3A gene is not associated with gastric cancer. PMID: 29956566
- concluded that miR-876-5p suppressed hepatocellular carcinoma progression by targeting DNMT3A PMID: 29724530
- These findings indicated a novel mechanism by which EID3, a p300 acetyltransferase inhibitor, could directly affect DNMT3A, this enzyme possesses dual methylation and demethylation abilities. PMID: 28074931
- DNMT3A R882 mutation plays an important role in CN-AML patients' prognosis and clinical outcomes in the presence and absence of NPM1 and FLT3 mutations. PMID: 29079128
- a feedback loop between miR-145 and DNMT3A is a potent signature for the Warburg effect in ovarian cancer, promising a potential target for improved anticancer treatment. PMID: 29993160
- In univariable analysis, patients carrying mutations in DNMT3A, U2AF1, and EZH2 had worse overall and relapse-free survival. PMID: 29321554
- Elastic Network Models, information theory, Protein Structure Network, and sequence evolution analysis were used to investigate intrinsic dynamics and allosteric properties of DNMT3A resolved in autoinhibitory and active states. The conformational transition between 2 states shows global motions. The dimer interface has a major role in defining the quaternary structure dynamics and establishing interdomain communication. PMID: 29674125
- HIF1A-AS2 exerted the oncogenic functions in CRC through regulating miR-129-5p/DNMT3A axis. PMID: 29278853
- we found that DNMT3A was responsible for the down-regulation of miR-105 in gastric cancer cells PMID: 28829505
- Taken together, these data demonstrate that adipose Dnmt3a is a novel epigenetic mediator of insulin resistance in vitro and in vivo. PMID: 29091029
- Low frequency of DNMT3A mutations in pediatric T-ALL is in striking contrast to adult T-ALL and renders the necessity for the search of other candidate prognostic markers. Combined Sanger sequencing-HRM approach offers a cost-effective option for genotyping DNMT3A coding sequence, with potential clinical application in other hematological malignancies. PMID: 28905428
- 2.65-angstrom crystal structure of the DNMT3A-DNMT3L-DNA complex in which two DNMT3A monomers simultaneously attack two cytosine-phosphate-guanine (CpG) dinucleotides, with the target sites separated by 14 base pairs within the same DNA duplex; mechanistic basis for DNMT3A-mediated DNA methylation and establishment of its aetiological link to human disease PMID: 29414941
- based on the investigation of previously reported variants in patients with Tatton-Brown-Rahman syndrome , we found overlap in the spectrum of DNMT3A variants observed in this disorder and somatic variants in hematological malignancies PMID: 28941052
- The emodininduced downregulation of UHRF1 led to an increase in the level of DNA methyltransferase 3A. PMID: 28901428
- Data suggest that miR-200b-3p may exhibit targeting and suppressive effects on DNA methyltransferase 3A (DNMT3A). PMID: 28345813
- Prostaglandin E2 promotes the acquisition of DNMT3A-dependent tolerogenic functions in human myeloid-derived suppressor cells. PMID: 28978469
- human mammary epithelial cells reprogramming is dependent on gene silencing by the DNA methyltransferase DNMT3A and loss of histone transcriptional marks following downregulation of the methyltransferase DOT1L. PMID: 28781076
- the immunohistochemical expressions of Klotho and DNMT3a in tissues obtained from oral dysplasia and oral squamous cell carcinoma, is reported. PMID: 28303350
- this epigenetic antagonism precedes malignant transformation and can be observed in preleukemic LSK cells from Idh2(R140Q) or Dnmt3a(R882H) single-mutant and Idh2(R140Q)/Dnmt3a(R882H) double-mutant mice. IDH/DNMT3A double-mutant acute myeloid leukemia (AML)manifested upregulation of a RAS signaling signature and displayed unique sensitivity to MEK inhibition ex vivo as compared with AMLs with either single mutation. PMID: 28408400
- The current findings confirmed that downregulation of DNMT3A protein expression and the ensuing disturbance of the maintenance DNA methylation may serve an important role in the pathogenesis of early embryo growth arrest. PMID: 28560437
- Our results provided novel insight into the role of the DNMT3A R882H mutation in AML pathogenesis and suggested that targeting the cellular GSH synthetic pathway could enhance the current therapy for AML patients with the DNMT3A R882H mutation. PMID: 28418922
- data confirm MLL-PTD and, to a lesser extent, FLT3-ITD as common events in +11 AML.6, 7, 8 However, the high mutation frequencies of U2AF1 and genes involved in methylation (DNMT3A, IDH2) have hitherto not been reported in +11 AML PMID: 27435003
- Silencing DNMT3A inhibits proliferation and invasion in ESCC cells by inducing demethylation of DOK7. PMID: 28343076
- Data show that DNA methyltransferase 3A (DNMT3A) mutation was significantly associated with adverse outcome in addition to conventional risk stratification. PMID: 27359055
- DNMT3A polymorphisms may be potential predictive markers for acute myelogenous leukemia patients' outcomes in China PMID: 27528035
- this study shows that DNMT3A mutations are present in a significant proportion of SF3B1mut patients with RARS and its presence has a clearly negative impact on outcomes, determining a higher RBC transfusion dependency, higher risk of progression to AML, and lower OS. PMID: 27771989
- DNMT3A is a de novo DNA methyltransferase that has recently gained relevance because of its frequent mutation in a large variety of immature and mature hematologic neoplasms. DNMT3A mutations are early events during cancer development and seem to confer poor prognosis to acute myeloid leukemia patients making this gene an attractive target for new therapies. [review] PMID: 28003281
- the present cohort study demonstrated that FLT3-ITD and DNMT3A R882 double mutation predicts poor prognosis in Chinese AML patients receiving chemotherapy or allo-HSCT treatment. PMID: 28616699
- propose a model of the DNMT3A PWWP domain-H3K36me3 complex and build a model of DNMT3A (PWWP-ADD-CD) in a nucleosomal context PMID: 26993463
- DNMT3 mutation in OCI-AML3 strain enhances leukemic aggressiveness by promoting extramedullary infiltration process, which is partially through upregulating TWIST1. PMID: 27724883
- Concurrent STAT3, DNMT3A, and TET2 mutations in T-LGL leukemia with molecularly distinct clonal hematopoiesis of indeterminate potential PMID: 27761930
- No evidence for genetic variants in DNMT3A being implicated in cognitive performance decline in individuals with mild cognitive impairment. PMID: 27092400
- A Methylated DNA Quantification Kit was used to quantify global DNA methylation, and single nucleotide polymorphisms (SNPs) in DNMT3A (rs36012910, rs1550117, and R882) and DNMT3B (rs1569686, rs2424909, and rs2424913) were identified using the restriction fragment length polymorphism method PMID: 28945286
- DNMT3A1 and DNMT3A2V were detected in newly diagnosed acute myeloid leukemia (AML) patients and controls, with DNMT3A2V significantly up-regulated in AML patients. The main transcript switched from DNMT3A1 to DNMT3A2V in some patients, especially the low risk group based on the NCCN 2016 guidelines. These findings suggest that DNMT3A1 and DNMT3A2V are the main variants in AML. PMID: 29024628
- Mechanical compression induced miR-9 downregulation by DNMT3A-dependent promoter methylation. PMID: 28252641
- TP(thymidine phosphorylase ) curbed the expression of three proteins-IRF8, RUNX2, and osterix. This downregulation was epigenetically driven: High levels of 2DDR, a product of TP secreted by myeloma cells, activated PI3K/AKT signaling and increased the methyltransferase DNMT3A's expression. PMID: 27658717
- alterations in DNMT3A and TET2 may be associated with acute myeloid leukemia prognosis PMID: 28992762
- Mutation in the DNMT3A gene is associated with acute myeloid leukemia patients with lympho-myeloid clonal hematopoiesis. PMID: 27881874
- These data demonstrate that haploinsufficiency for Dnmt3a alters hematopoiesis and predisposes mice (and probably humans) to myeloid malignancies by a mechanism that is not yet clear. PMID: 28872462
- This report represents the first documentation of the same variant (DNMT3A p.Arg882His) as both the constitutional mutation associated with TBRS and the somatic mutation hotspot of AML. PMID: 27991732
- Mutations in genes associated with epigenetic regulations such as DNMT3A and ASXL1 seem to play an important role in the pathogenesis of CML progression and TKI-resistance independent of ABL1 KD mutations PMID: 28667884
- Dnmt3a2 is at the core of memory processes and represents a novel target for cognition-enhancing therapies to ameliorate anxiety and fear disorders and boost memory consolidation. PMID: 26598069
- Data indicate that DNMT3A allele G of rs1550117 was associated with an increased risk of non-small cell lung cancer (NSCLC) susceptibility and binding affinity of transcription repressor SP1. PMID: 28423585
- The results show that DNMT3A mutations are associated with an unfavourable clinical outcome in our Southeast Asian AML patient cohort. PMID: 28100593
- DNMT3A mutations were rare in Chinese children with acute myeloid leukemia (AML). The mutation positions were different from the hotspots reported in adult AML. DNMT3A mutations may have adverse impact on prognosis of children with AML. PMID: 28767575
顯示更多
收起更多
-
相關(guān)疾病:Tatton-Brown-Rahman syndrome (TBRS)
-
亞細胞定位:Nucleus. Chromosome. Cytoplasm.
-
蛋白家族:Class I-like SAM-binding methyltransferase superfamily, C5-methyltransferase family
-
組織特異性:Highly expressed in fetal tissues, skeletal muscle, heart, peripheral blood mononuclear cells, kidney, and at lower levels in placenta, brain, liver, colon, spleen, small intestine and lung.
-
數(shù)據(jù)庫鏈接:
Most popular with customers
-
-
Phospho-YAP1 (S127) Recombinant Monoclonal Antibody
Applications: ELISA, WB, IHC
Species Reactivity: Human
-
-
-
-
-
-